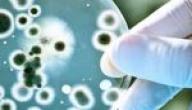

محتويات
منع الحمل
منع الحمل أو تنظيم الولادة والحمل هو استخدام الطرق الطبية أو الطبيعية أو غيرها في منع حدوث الحمل مع الإبقاء على النشاط الجنسي الطبيعي عند المرأة، ويطلق عليه أيضًا اسم تنظيم الأسرة أو تنظيم الفعالية الجنسية، وتعتمد وسائل منع الحمل الحديثة -كانت أو القديمة- على عدة محاور، إما منع البويضة من أن يتم إصدارها من المبيض، أو منع انغراس البويضة الملقحة وتعشيشها ضمن الرحم، أو يمكن أن تعتمد وسائل منع الحمل أيضًا على منع وصول النطاف إلى البوقين حيث يتم التلقيح، ويمكن لوسائل منع الحمل أن تكون قابلة للعكس أو نهائية غير قابلة للعكس. [١]
فوائد حبوب منع الحمل
لا تقتصر وسائل تنظيم الأسرة على مجرد منع حدوث الحمل عند المرأة، بل يمكن أن تساعد في كثير من الأمراض أو الحالات الطبية الأخرى، حيث تُقدّر نسبة السيدات اللواتي يتناولن حبوب منع الحمل لأسباب أخرى بغض النظر عن منعها للحمل بحوالي 14%، وهي نسبة ليست بالقليلة، فمن فوائد منع الحمل الأخرى ما يأتي: [٢]
تنظيم الدورة الشهرية
يمكن لحبوب منع الحمل أن تُساعد في تنظيم الدورة الشهرية بشكل كبير، حيث تستطيع المرأة معرفة توقيت حصول الدورة بدقّة عبر تناولها للحبوب التي تُحدث الطمث، حيث تحوي حبوب منع العمل التقليدية هرموني الإستروجين والبروجسترون بنسب متفاوتة بين الأيام، حيث تحوي الحبوب فعالية في أول ثلاثة أسابيع، ثم تتلوها الحبوب عديمة الفعالية في آخر أسبوع مما يُحدث الطمث، كما تتنوع وسائل منع الحمل الحديثة التي عن طريق الحبوب في إحداث الدورة، حيث تستطيع المرأة أن تقوم بتنظيم دورتها بحسب ما يتوافق مع برنامج حياتها ونظامها.
المساعدة في مشاكل الدورة الحالية
يمكن أن تساعد حبوب منع الحمل في تخفيف المشاكل التي تصيب المرأة أثناء دورتها الحالية، حيث يمكنها أن تسيطر على النزف الشديد الحاصل -أو الطمث الغزير-، وذلك بمنع الإباضة وجعل البطانة الرحمية بسماكة قليلة، كما تخفض الحبوب من احتمالية حدوث فقر الدم بعوز الحديد، والذي ينجم عن النزف المزمن، كما يمكن لهذه الحبوب أن تخفف من التقلصات العنيفة في عضلة الرحم أثناء الطمث في الدورة الشهرية، ولحبوب منع الحمل فعالية كبيرة في تخفيف أعراض متلازمة ما قبل الطمث PMS، كالمزاج المتقلّب وتوتّر الثديين وكسب الوزن وانتفاخ القولون وحبّ الشباب، وذلك عن طريق إحداث التوازن الهرموني ضمن الدورة.
تخفيف أعراض الإندومتيروز والوقاية من كيسات المبيض
الإندومتريوز هو حالة من هجرة بطانة الرحم إلى مناطق خارجه ضمن الجسم، ويمكن لحبوب منع الحمل أن تُخفف من أعراضه دون علاجه، كما تساعد في الوقاية من تشكّل كيسات المبيض أو نكسها.
تنظيف البشرة ومنع نمو الشعر غير المرغوب
يمكن لحبوب منع الحمل أن تساعد في تحسين أعراض حب الشباب وتخفيف نمو الشعر الزائد، وذلك بخفض إنتاج المبيضين لتلك النسبة القليلة من الهرمونات الذكرية، كما يمكن أن تساعد في منع تشكل حب الشباب الجديد إلّا أن هذا الأمر قد يستغرق عدّة أشهر حتى يحدث.
تحسين أعراض متلازمة المبيض متعدد الكيسات
قد تساعد حبوب منع الحمل في تخفيف أعراض متلازمة المبيض متعدد الكيسات PCOS، وذلك بتحسين التوازن الهرموني وتخفيف إنتاج الجسم للتستوسترون وتنظيم الدورة الشهرية.
الوقاية من بعض السرطانات
يمكن لتناول حبوب منع الحمل أن يحمل خطورة حدوث بعض أنواع السرطانات، لكنه بالمقابل يقي من أنواع أخرى منها، فالنساء اللواتي تناولن حبوب منع الحمل لديهنّ فرصة تطوير سرطان المبيض بنسبة أقل بحوالي 30 إلى 50 بالمئة من غيرهن، وهذا يعتمد على مدّة تناول الحبوب، كما أن لهذه الحبوب دورًا في خفض نسبة حدوث سرطان باطن الرحم.
الآثار الجانبية لحبوب منع الحمل
يمكن لجميع وسائل منع الحمل الهرمونية أن تسبّب آثارًا جانبية، وذلك سواء كانت الوسيلة حبوبًا أو لصاقات أو عن طريق اللولب الهرموني، ولكن معظم هذه الآثار الجانبية تزول بعد شهرين إلى ثلاثة أشهر من بدء منع الحمل، ومن الآثار الجانبية لوسائل منع الحمل الهرمونية ما يأتي: [٣]
- حبّ الشباب.
- النزف أو التنقيط الدموي بين الطموث.
- انتفاخ القولون.
- ارتفاع ضغط الدّم فوق مستواه الطبيعي.
- الاكتئاب.
- الإرهاق.
- الشعور بالدوخة.
- احتباس السوائل.
- الصداع.
- زيادة الشهية الطعامية.
- الأرق.
- الكلف.
- تبدّلات المزاج.
- الغثيان والإقياء.
- ألم وقساوة الثديين.
- كسب الوزن.
عند كون هذه الأعراض شديدة أو استمرارها أكثر من ثلاثة أشهر بعد البدء بمنع الحمل يجب استشارة الطبيب لمحاولة تغيير الطريقة.
أنواع وسائل منع الحمل
تحمل وسائل منع الحمل الحديثة أو التقليدية عدّة أساليب في سبيل تنظيم الأسرة، منها ما يمنع النطاف من الوصول إلى البويضة، وهذا ما يُعرف بالوسائل الحاجزية، ومنها ما يمنع الإباضة، ومنها ما يمنع تعشيش البويضة الملقّحة في بطانة الرحم، كما أنّ هناك بعض الوسائل الجراحية في منع الحمل والتي تعتبر وسائل نهائية، وذلك للأشخاص غير الراغبين في الإنجاب بشكل نهائي بقية الحياة، وبذلك يمكن تصنيف وسائل منع الحمل على الشكل الآتي: [٤]
- وسائل منع الحمل الهرمونية:
- حبوب منع الحمل.
- لصاقات منع الحمل.
- غرسات منع الحمل.
- الحلقة المهبلية.
- وسائل منع الحمل الحاجزية:
- الأحجبة الحاجزة.
- الواقي الذكري.
- قبّعات عنق الرحم.
- المبيدات المنوية.
- وسائل منع الحمل الطبيعية، والي تشمل استخدام:
- فحوصات موعد الإباضة.
- فحص مخاط عنق الرحم.
- تتبّع الدورة الشهرية.
- وسائل أخرى في منع الحمل:
- الأجهزة ضمن الرحم، كاللولب.
- حبوب منع الحمل الإسعافية التي تلي الجماع غير المُمنّع.
- وسائل منع الحمل الدائمة الجراحية:
- ربط البوقين عند المرأة.
- قطع الأسهر -أو ما يُعرف بقطع القناة الدافقة- عند الرجل.
وسائل منع الحمل الحديثة
قد تم تصنيف وسائل تنظيم الأسرة بحسب منظمة الصحة العالمية WHO إلى صنفين أساسيين، وسائل منع الحمل الحديثة ووسائل منع الجمل التقليدية، وتشمل الأخيرة طريقتين رئيستين وهما: قطع الجماع -أو الجماع المبتور- وتتبّع الدورة الشهرية، أمّا فيما يخص وسائل منع الحمل الحديثة فقد تم وضعها -مع فعالية كل منها في منع الحمل- على الشكل الآتي: [٥]
- حبوب منع الحمل المشتركة: وتحوي هذه الحبوب على الإستروجين والبروجيسترون، وتبلغ فعالية استخدامها أكثر من 99% عد الاستخدام الصحيح.
- الحبوب البروجسترونية: وتحوي البروجسترون دون الإستروجين، تبلغ فعاليتها 99% عند الاستخدام الصحيح.
- الغرسات: وهي قطع صغيرة من مواد تحتوي على البروجسترون فقط وتُزرع أعلى الذراع، ميزتها أنّها يمكن أن تستمر فعالية الغرسة الواحدة من 3 إلى 5 سنوات، وتبلغ فعاليتها أكثر من 99%.
- الحقن البروجسترونية: وهي حُقن عضلية أو تحت الجلد لأدوية حاوية على بروجسترون، وتُستخدم كل شهرين إلى ثلاثة أشهر، وتبلغ فعاليتها أكثر من 99% عند الاستخدام المستمر والصحيح.
- اللصاقات المشتركة وحلقات المهبل المشتركة: وتقوم بطرح البروجسترون والإستروجين عبر البشرة، وتحتاج نسبة فعاليتها إلى المزيد من الدراسة.
- اللولب الهرموني: وهو جهاز صغير على شكل حرف T يتم وضعه في الرحم تحت إشراف طبي، ويحوي مادّة الليفونورغيستريل، وتبلغ نسبة فعاليته أكثر من 99%.
- الواقي الذكري: وهو غشاء أو غطاء مطاطي القوام يوضع على القضيب قبل الجماع، تبلغ نسبة فعاليته 98% عند الاستخدام المستمر والصحيح.
- الواقي الأنثوي: وهو غطاء أو بطانة مطاطية توضع في المهبل، تبلغ نسبة فعاليته 90% عند الاستخدام المستمر والصحيح.
- التعقيم الذكري -قطع الأسهر-: وذلك عن طريق القطع الجراحي للأسهرين، واللذان يحملان النطاف من الخصيتين إلى القناة الدافقة، وتبلغ نسبة فعاليته أكثر من 99% بعد 3 أشهر من العملية.
- التعقيم الأنثوي -ربط البوقين-: وهو القطع الدائم للقناتين الناقلتين للبيوض، وتبلغ نسبة الفعالية أكثر من 99%.
- الإرضاع: أي عند النساء الولودات حديثًا ولم تعود الدورة الشهرية لديهنّ بعد، حيث يمكن استخدام هذه الطريقة عند إرضاع طفل أصغر من 6 أشهر بشكل دائم ليلًا نهارًا بحسب رغبته، وتبلغ نسبة الفعالية 99% عند الاستخدام الصحيح والمستمر.
- حبوب منع الحمل الإسعافية: والتي يتم استخدامها بعد الجماع غير المُمنّع بفترة تقل عن 5 أيام، تبلغ نسبة فعاليته حوالي 99%.
- طريقة قياس درجة حرارة الجسم: وذلك عندما تقيس المرأة درجة حرارة جسمها طيلة فترة الدورة كل صباح لتراقب ارتفاع الحرارة بمقدار 0.25 إلى 0.5 درجة، حيث يشير ذلك إلى موعد حدوث الإباضة، وتبلغ نسبة الفعالية 99% بالاستخدام الصحيح.
- طريقة اليومان: وذلك بمتابعة المرأة لمخاط عنق الرحم كل يومين لمراقبة التغير الحاصل فيه، وتبلغ نسبة الفعالية حوالي 96%.
- طريقة الأعراض والحرارة: وتعتمد هذه الطريقة على مراقبة عدة أمور من ضمنها أعراض الدورة وقياس درجة الحرارة ومخاط عنق الرحم وغيرها، وتبلغ نسبة فعاليتها 98% عند الاستخدام الصحيح والمستمر.
ويجب التنويه إلى أنّ نسب الفعالية المذكورة أعلاه يمكن أن تتغير بحسب صحة تطبيق وسيلة منع الحمل والالتزام بها، فعلى سبيل المثال، تنخفض نسبة فعالية الواقي الذكري من 98% إلى 85% عند استخدامه المتقطّع غير المستمر.
المراجع[+]
- ↑ Medical Definition of Birth control, , "www.medicinenet.com", Retrieved in 06-01-2019, Edited
- ↑ Birth Control: Benefits Beyond Pregnancy Prevention, , "www.webmd.com", Retrieved in 06-01-2019, Edited
- ↑ What Are the Side Effects of Birth Control Pills?, , "www.healthline.com", Retrieved in 06-01-2019, Edited
- ↑ 15 Birth Control Options (Types and Side Effect), , "www.medicinenet.com", Retrieved in 06-01-2019, Edited
- ↑ Family planning/Contraception, , "www.who.int", Retrieved in 06-01-2019, Edited